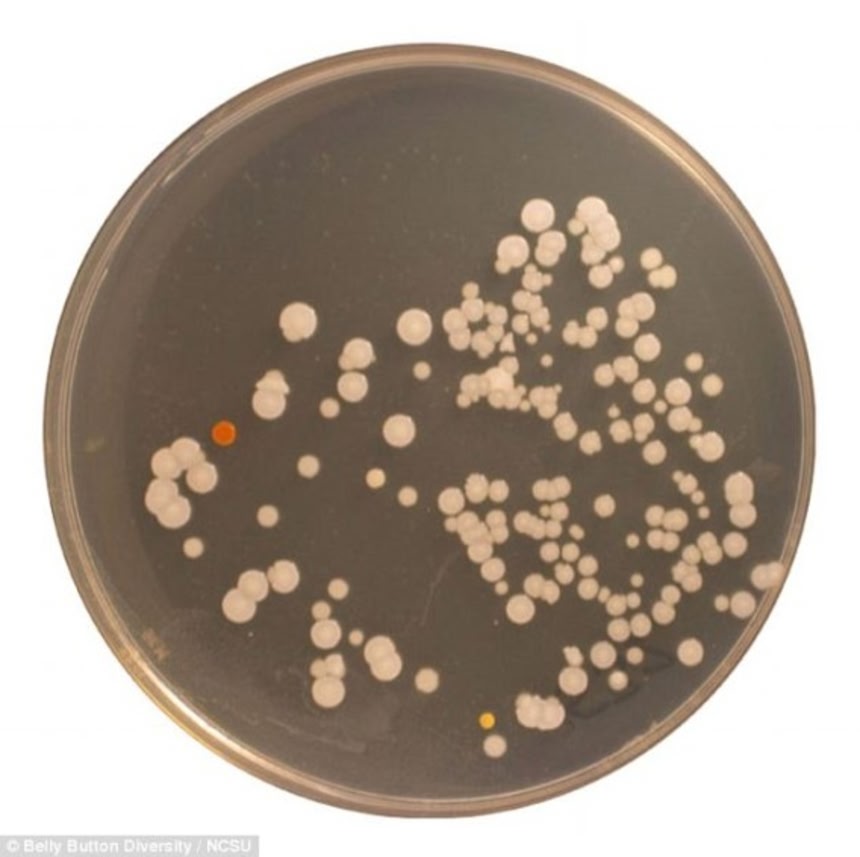
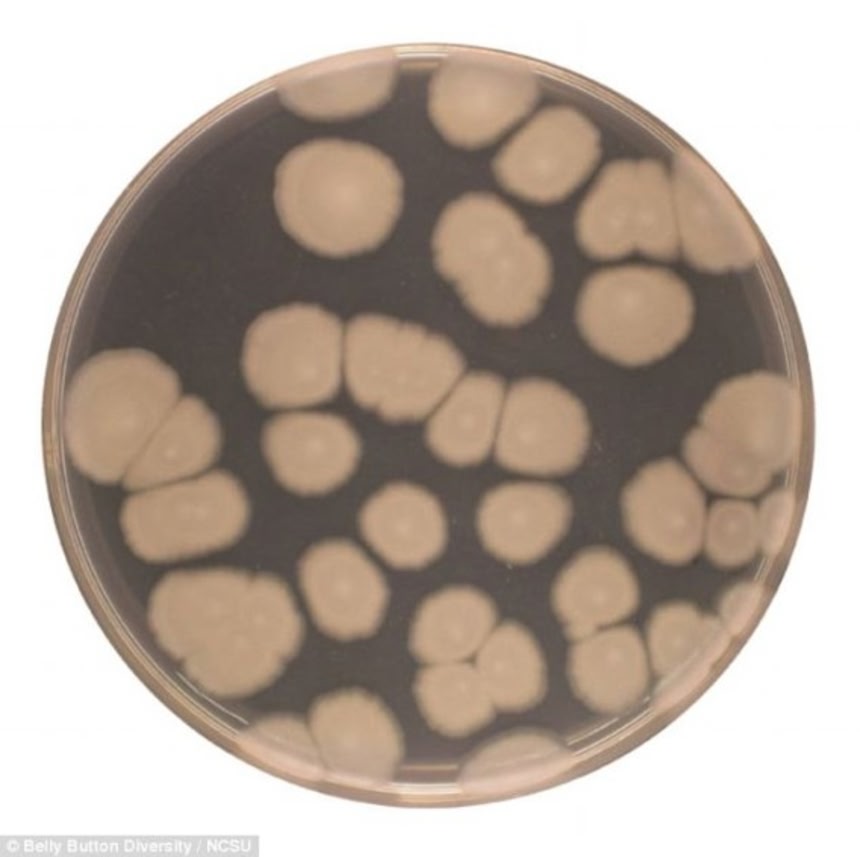

この画像を大きなサイズで見る
この画像を大きなサイズで見る人間は平均で約60種のバクテリアをへそに住まわせているそうだ。しかしその種類は人によって異なるのだそうで、60人を対象とした調査で発見されたバクテリアの種類はなんと2368種。そのうち1458種は新種の可能性があるというのだから、調査対象人数をもっと増やしたら、まだまだ増えそうな気配。
人間のヘソは、まるで熱帯雨林のような豊かな生態系をもっているのだ。
米ノースキャロライナ州立大学の生物学者のロブ・ダン氏は、へその生物多様性を研究することを目的としたプロジェクト、「ベリーボタン2.0(Belly Button 2.0)」を始動させた。生態学者チームが60人のボランティアからサンプルを集めたところ、予想以上に多種多様のバクテリアが発見された。
細菌は少ない人では29種、多い人では107種もいたが、平均では約67種が見つかった。そのうちの92%の細菌種は、サンプル提供者全体の10%足らずにしか存在しなかった。これはすなわち、ほとんどの細菌種が60人中1人からしか見つからなかったことを意味する。
ヘソから発見されたグラム陽性細菌に分類される真正細菌 マイクロコッカス属
この画像を大きなサイズで見る
この画像を大きなサイズで見る例えば、あるサイエンスライターからは、これまで日本の土壌でしか発見例のない細菌と思しき種が見つかったが、この人物は日本への渡航歴はなかった。そのほか、数年間へそを洗っていないという、かぐわしい人物からは、いわゆる極限環境微生物2種が見つかった。通常は氷冠や熱水噴出孔などの過酷な環境に生息するものだ。
このように多様性に富んだ細菌が見つかったが、調査結果からは特定の傾向も浮かび上がった。被験者全員が共通して持っている菌は1つもなかったが、70%以上の被験者が共通して持っていた8種の菌は、その被験者のヘソの中に大量に存在した。
「この点において、へそは熱帯雨林とよく似ている」とダン氏は述べる。熱帯雨林は1つ1つが異なる植物相を持つが、どの熱帯雨林にも共通して豊富に存在する樹種がいくつかあるのだという。
この画像を大きなサイズで見る
この画像を大きなサイズで見るダン氏の研究チームは、より多くの人のへそを調べる作業に入っており、間もなくその数は600人に達する。チームは新たなサンプルを使って、へそに生息するバクテリアがサンプル提供者の出生地や免疫系などとどのように関連しているのかを調べる計画だという
 この画像を大きなサイズで見る
この画像を大きなサイズで見るこのような関連性を明らかにすることは、人間に宿る細菌が健康にもたらす影響を知るうえで役立つ可能性がある。へそに限らず、およそ人間の体に存在する微生物は、その人の免疫機能からニキビ、肌の柔らかさにまで影響を及ぼしていると考えられている。そもそも微生物がそこで何をしているのか、なぜそこにいるのかをまず理解することで、医学に役立てたいとしている。
via:dailymail
ヘソっの中にいる数十種のバクテリアはみんなそれぞれに違った種類のものがいて、そこで生態系を形成して仲良く暮らしているわけで、進化したり絶滅したりを繰り返しながら、毎日暮らしているかと思うと、ゾクゾクするね。バクテリアが肉眼で見えないのが悔やまれる。誰かヘソを舞台にした、バクテリアたちの悲喜こもごもを映画とか漫画とかゲームにしてくれないかな。そうしたらもっとバクテリアたちとわかりあえるかも。
















>数年間へそを洗っていないという、か ぐわしい人物からは、
>いわゆる極限環境微生物2種が見つかった。通常は氷冠や熱水噴 出孔
>などの過酷な環境に生息するものだ。
スゲェ
へーそーなんだ
未踏のフロンティアがまだまだあるもんですねええ~
猛獣とか居ると面白いけどでも、新分野が出来そう
ニキビ全然できない人のバクテリア移植したい
2、3日風呂に入んないとヘソ 臭がハンパないことになるもんな
バク・テリアさんの記事は例外なくおもろいしためになる。
俺のへそを見たら、ごまがいっぱいあったワ。
誤魔化しができないのが不思議だ。
女のヘソを舐めるのが好きなんですが・・・
やめろ・・・やめろ・・・
家族だと似たりすんのかねー
へそって火山の噴火口くらい劇的な場所なのか
なるへそ
毎日お風呂入ったとき石鹸で洗ってるけど、それでもいるんだろうな・・
こういうのを読むと、アレルギーが爆発的に日本で増えたのって
清潔にしすぎだからじゃないかと思う
不潔くらいが人間にとって調度いいんじゃないか?
ヘェーヘェーヘェー
足親指の爪の垢もそうなんだろうな…
なんと……。
ではヘソを指でほじくっている時は、さしずめ巨大ブルドーザーに伐採されている熱帯雨林状態なワケだ。
おへその中には何がある♪
毎日へそをひっくり返して表面をそぎとるんだがそれでもいるんだろうな…
へそって意識して洗ったこと無いな…
ちょっと風呂入ってくる
洗ったことないけど
俺のへその中には何もいないはず、
決して俺は信じない。
米20
凹んでいる臍を押し出して出べそに出来るって事でしょ
んで中を掃除出来るってこと
おい、「もやしもん」の作家にこのアイデア送ってやれよ!!
へそにゴマが溜まった事無い…半でべそというか、穴になってないから
おへその中にはゴマがある♪♪
ヘソのゴマの中にいるのか!
へそはあんまりグリグリいじくっちゃいかん!と聞いたが
・・・これ、誰が撮影したんだろ
風呂に入らない男女のへそからサンプルとればすごい珍しいの取れるんじゃない?
バクテリアを食べる生物を臍の中に入れてみよう
宇宙と人間は相似構造であるなんて神秘学の説を思い出すなあ。
俺のへそオープンエアタイプなんだよな。でべそってわけでもないし
免疫バンクみたいなもんなんだろうか?
住環境が変わると皮膚上の常在菌が入れ替わったりするんだろうか?
>凹んでいる臍を押し出して出べそに出来るって事でしょ
皮膚がよく伸びて柔らかい人なら出来るのかな?
裏から押して凹を凸にするんだよね?昔あったジャンプするゴムのオモチャみたいな